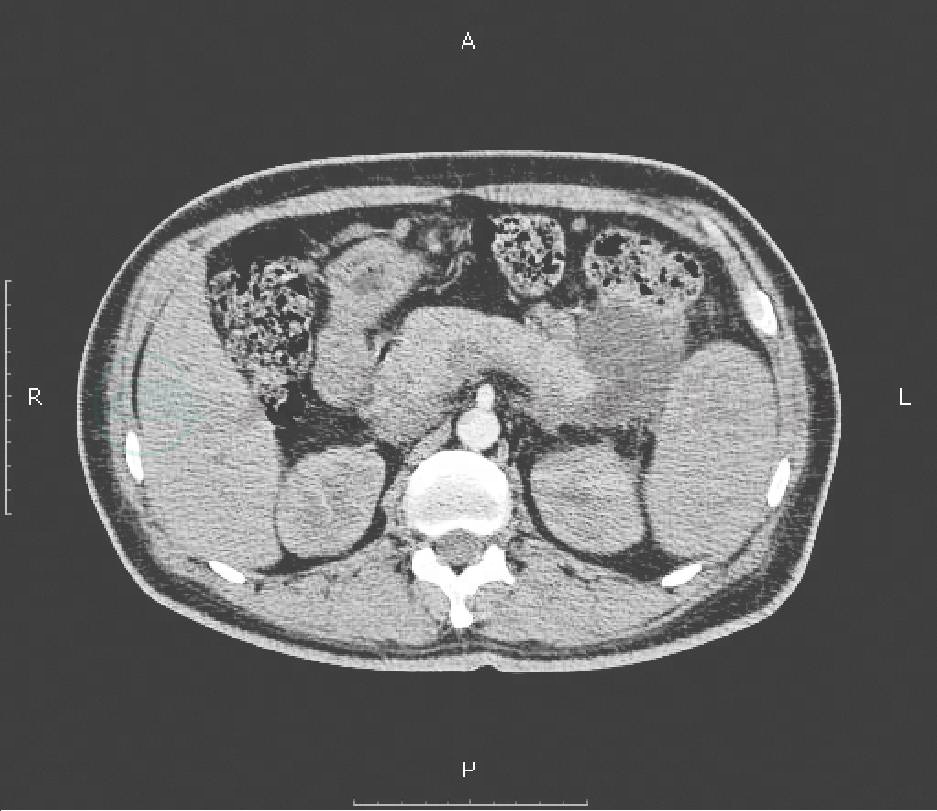

难点:以上消化道出血为首发表现的胰源性左侧门脉高压症诊断;非单纯机械性囊肿压迫所致脾静脉阻塞的治疗原则。
患者,男,48岁,于2007-03-06入院。
(一)主诉
间断黑便3个月,呕血1次。
(二)现病史
患者3个月前解成形黑便,每天1~2次、大约100g左右,伴头晕、乏力,外院查大便隐血阴性,考虑“血液系统疾病”,检查铁代谢、叶酸及维生素B12均正常,Coombs试验阴性,骨髓穿刺结果正常,予输血治疗后好转。2个月前再解黑便、并呕血1次,量少约50ml,无腹痛、腹泻、腹胀,外院胃镜诊断胃底静脉曲张伴出血转诊南京大学医学院附属鼓楼医院,行超声胃镜示胃底静脉曲张,胰腺假性囊肿,为进一步诊治收住消化科。
(三)既往史
患者自2002年至今急性胰腺炎发作5次,原因不明;无饮酒史;糖尿病病史。
(四)查体
T:37℃,P:96次/分,R:18次/分,BP:118/57mmHg。神清,贫血貌,全身浅表淋巴结未触及肿大。心肺正常,腹平软,腹壁静脉未见曲张,无压痛及反跳痛,肝肋下未触及,脾肋下2cm。Murphy征阴性,肝肾区无叩击痛,移动性浊音阴性,肠鸣音3次/分,四肢无水肿。
(五)辅助检查
血常规:WBC 2.2×109/L,N 58%,Hb 35g/L,HCT 11.7%,MCV 67.6fl,MCH 20.3pg,MCHC 301g/L,PLT 218×109/L。粪常规正常。尿常规:尿糖(+),其他正常。生化全项:A 35.8g/L,BG 8.23mmol/L,TC 1.97mmol/L,HDL-C 0.33mmol/L,LDL-C 0.30mmol/L,其他正常。凝血三项:正常。空腹C肽:1371pmol/L。餐后C肽:1311pmol/L。糖化血红蛋白:5.8%。
腹部CT平扫+增强:胰尾部囊性低密度影,考虑胰腺假性囊肿(图1),胃底静脉轻度曲张,脾脏肿大。
胃镜:食管各段黏膜色泽正常,未见溃疡与异常隆起。贲门无异常。胃底可见曲张静脉,胃腔内有新鲜血迹,胃体、胃角黏膜光滑,胃窦黏膜红白相间。印象:胃底静脉曲张。超声胃镜:胃底病变处可见扩张的静脉管腔,位于黏膜下层。胰尾部可见一个5.5cm×3.2cm液性暗区,包膜完整,胰管无扩张。
图1 CT示胰尾部假性囊肿
1.入院诊断 胃底静脉曲张伴出血,胰腺假性囊肿;重度小细胞低色素性贫血;糖尿病。
2.入院后上级医生查房分析 该患者因反复上消化道出血入院,超声胃镜示胰尾部可见5.5cm×3.2cm液性暗区,胃底可见扩张的静脉管腔,诊断孤立性胃底静脉曲张及胰尾假性囊肿,结合其既往多次发作胰腺炎病史,而无肝病病史,考虑胃底静脉曲张为左侧门脉高压症引起,后者因胰腺假性囊肿压迫了脾静脉所致。为排除脾静脉血栓引起脾胃性高压,应行彩超检查,若脾静脉管腔内无血栓回声,可考虑行“经胃胰腺假性囊肿穿刺引流术”,这样能解除囊肿对脾静脉的压迫,从而解除胃底静脉曲张。
3.脾静脉彩超 脾静脉直径1.04cm,内部透声好,脾门处静脉走行弯曲,血窦形成,频谱呈双向改变。结果提示存在门静脉高压,但是脾静脉无血栓形成。由于B超未见脾静脉血栓,于2007-03-22行胃镜下胰腺假性囊肿穿刺双猪尾支架置入胃-囊肿内引流术,在UCT 2000下,见胰尾部假性囊肿,选择适当穿刺点,确定穿刺深度,用穿刺针穿刺至囊肿内,沿穿刺针置入导丝,沿着导丝置入针状刀,切开,分别用6F、7F扩管扩张,然后用气囊扩张,再沿着导丝置入双猪尾支架(图2),见大量囊液流出,引流液培养阴性。术后第1天患者出现发热,体温最高达39℃,伴畏寒、寒战,血培养阴性,加强抗感染及支持治疗,于术后第3天体温降至正常。
4.于入院26天复查超声胃镜 胃底胃体可见大量咖啡色血迹附着,胰尾部未见明显液性暗区,胰腺包膜完整,胰管无扩张。期间患者仍间断解黑便,予以输血、抑酸、降门脉压治疗效果不佳,多次查血常规示:WBC(1.7~6.18)×109/L,Hb(50~84g/L,PLT)(146~208)×109/L。入院43天复查腹部CT+三维重建示:肝、胆、胰及双肾正常,胰尾部假性囊肿消失,见支架(图3)。脾脏外形增大,胃壁增厚,增强静脉期见胃底静脉明显曲张,胃底周围可见强化血管。因假性囊肿引流术后胃底静脉曲张仍未见消失,科内讨论后建议外科手术(脾切+断流手术),患者和家属拒绝手术,要求内科保守治疗,经过与患方讨论后试行介入治疗。

图2 放置双猪尾内支架

图3 胰腺假性囊肿消失,见胰腺与胃壁之间的支架
5.入院70天行经皮、经肝胃底静脉栓塞术(PTVE) 术中门静脉主干测压为25cmH2O,造影见脾静脉近门脉段4cm明显狭窄,造影剂滞留于脾静脉残端,经导丝反复探查,通过狭窄处进入远端脾静脉达肝门部,交换微导管行脾门静脉造影,见脾门广泛侧支循环形成,并见胃短静脉扩张迂曲至胃底,形成胃底静脉丛,将微导管超选入扩张的胃短静脉进行栓塞治疗,注入鱼肝油酸钠10ml,并送入3cm×3cm钢圈2枚行封堵术。术后10天、30天再次解黑便,复查胃镜可见胃底曲张静脉,胃腔内有新鲜血迹,考虑栓塞治疗效果不佳,建议外科手术治疗。因其药物、超声内镜下胰腺囊肿支架引流及PTVE治疗效果不佳,为明确下一步治疗方案,全科讨论。
6.于入院102天全科讨论,内容如下
(1)甲医生:患者虽胃底静脉曲张明显,但出血原因还需考虑门脉高压性胃病所致。目前只有采取手术才能根本解决胃底静脉曲张,但手术风险较大,术前要充分做好各项准备,例如控制血糖及预测手术风险等。
(2)乙医生:患者PTVE效果不好,栓塞不彻底导致剩余血管压力变大,下一步可考虑脾脏切除或脾栓塞。
(3)丙医生:该患者左侧门脉高压症、胰腺假性囊肿、胃出血诊断明确,左侧门脉高压症、胰腺假性囊肿均为继发性改变。治疗考虑:这些患者的脾静脉常缩窄、甚至闭塞,30%胰腺假性囊肿内引流术后仍需手术,可采取脾切除术或胰体尾切除+脾切除术。脾切除术是治疗门脉高压症最有效方式,可迅速减少侧支循环血流,降低曲张静脉压力,减少出血。对于有胃底或食管静脉下段曲张静脉破裂出血的左侧门脉高压症患者除行切脾外还需行门、奇静脉断流术。该患者有手术指征,但由于其病程长,基础条件差,手术风险较大,需向患者及家属说明病情和预后。
7.家属要求出院,放弃治疗。